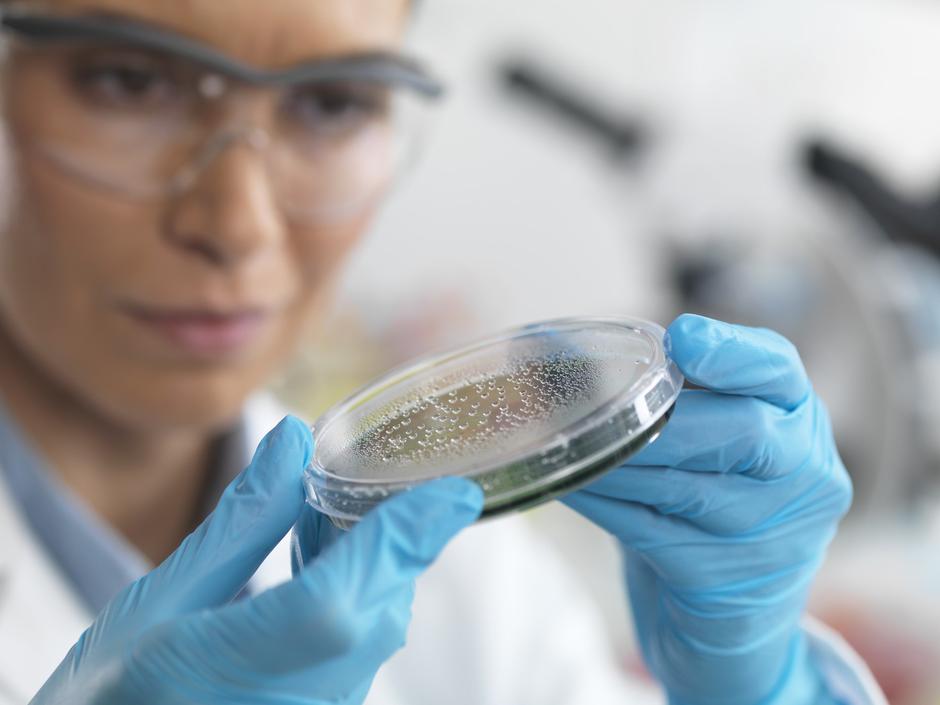

Projekt Genom Evrope (Genome of Europe, GoE) je začel raziskavo javne ozaveščenosti o genomiki v petih evropskih državah: Estonija, Francija, Grčija, Portugalska in Slovenija. Cilj raziskave je oceniti razumevanje državljanov in njihov odnos do genetike in na genomiki temelječe personalizirane medicine, so sporočili iz UKC Ljubljana, ki aktivno sodeluje v evropskem projektu Genom Evrope.
Cilj slovenske raziskovalne ekipe je, da pridobi genomske podatke vsaj 500 zdravih slovenskih prostovoljk in prostovoljcev ter jih vključi v skupno evropsko podatkovno zbirko projekta Genom Evrope.
Vse prostovoljke in prostovoljce, starejše od 40 let, ki jih to zanima, vabijo, da se prijavijo za sodelovanje v Slovenskem referenčnem genomskem projektu (SRGP). V drugi polovici leta 2026 jih bodo povabili na odvzem vzorca krvi za izolacijo DNK. Prijave sprejemajo na elektronskem naslovu: info.srgp@kclj.si.
Znanstvenica v laboratoriju - raziskuje mikrodelce
Znanstvenica v laboratoriju - raziskuje mikrodelce
"Raziskava je del širšega znanstvenega in družbenega prizadevanja, da bi vsi Evropejci lahko bili deležni koristi sodobne genomske medicine," so še sporočili iz UKC Ljubljana.
"Zaradi dostopnosti genomskih diagnostičnih postopkov, predvsem na ravni Univerzitetnega kliničnega centra Ljubljana, in zaradi aktivne vloge slovenskih raziskovalnih institucij v mednarodnih pobudah, je Slovenija danes uvrščena med najnaprednejše države na področju genomike v Evropi," so še zapisali.





